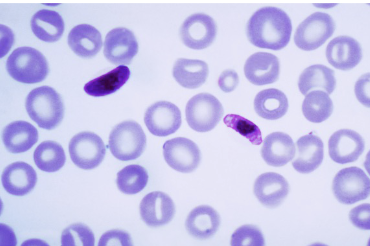
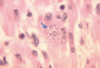
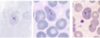
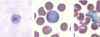

Entamoeba histolytica trophozoite

Entamoeba histolytica cysts
What is the life cycle of Entamoeba histolytica?
Cyst –> Excystation in small intestine –> metacystic amoeba

When is the infective stage of Entamoeba histolytica?
Cyst stage
Where are Entamoeba histolytica trophozoites found?
Large intestine and invade mucosa
How do you get infected with Entamoeba histolytica ?
Drinking fecal contaminated water
What is distribution of Entamoeba histolytica?
Worldwide distribution, but most common in tropical and subtropical areas
What is the source of Entamoeba histolytica?
Contaminated water, laundry, etc Contaminated food (vegetables, soil) Mechanical contamination (medical equipment)
What is pathology of Entamoeba histolytica?
Trophozoites adhere to epithelium –> forming an ulcer
Colitis (inflammation of colonic wall)
Liver lesions / abcess
Symptoms of Entamoeba histolytica
Diahrrea, dysentery, cramps, vomiting, malaise, abdominal discomfort
How do you diagnose Entamoeba histolytica?
Microscopy of pus or aspirate, stool examination
What is prognosis of Entamoeba histolytica?
90% recovery after treatment –> Metronidazole (10-25 mg/kg, PO,
bid x 1 wk)
Body will repair itself but repaired
connective tissue in bowel will not
function.

Entamoeba histolytica trophozoite

Entamoeba histolytica cyst
What is life cycle of Entamoeba coli?
Life cycle and location identical to Entamoeba histolytica
Is Entamoeba coli pathogenic?
No –> feeds on bacteria; does not invade tissue
Which is E. coli and which is E. histolytica?

Top –> E. coli
Bottom –> E. histolytica

Entamoeba coli cysts
How can you prevent Entamoeba infections?
1.Boil drinking water
2. Wash fruits and vegetables in clean water before eating
3. Detection and treatment of carriers and prohibit them
from food handling
4. Health education
What are the two main diseases Trypanosoma spp cause?
Sleeping sickness, Chaga’s dz
What is the main dz Plasmodium spp cause?
Malaria

Trypanosoma spp.:
•Sleeping sickness
•Chagas disease
Plasmodium spp.
•Malaria

- Leishmania spp.
* Leishmaniasi